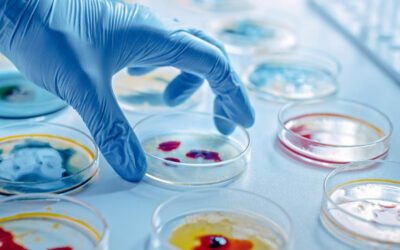
March 2025 Newsletter: Pharmalys takes over full management of the GCLP Accreditation Scheme, Corporate Social Responsibility

Recent Blog Posts
Pharmalys Supports #Red4Research: Celebrating the People Behind Groundbreaking Health Advances
At Pharmalys, we proudly stand alongside the global community championing health and social care research through the #Red4Research initiative. This movement honours the countless individuals, research participants, patients, healthcare professionals, volunteers, and...
Advancing African Clinical Research Capacity: Pharmalys at TCIS Africa 2025
Pharmalys was pleased to participate in TCIS Africa 2025, an important gathering of clinical research professionals from across the continent. The event underscored the progress being made in Africa’s research landscape, while also highlighting the essential work...
March 2025 Newsletter: Pharmalys takes over full management of the GCLP Accreditation Scheme, Corporate Social Responsibility
Pharmalys is pleased to announce that, effective from 2025, we have taken on the full management of the Good Clinical Laboratory Practice (GCLP) Accreditation Scheme, which we have co-managed with Tim Stiles of Qualogy 2002 Ltd for the past two years. This marks an...
May 2025 Newsletter: Senegal Achieves WHO Maturity Level 3, Improving Patient Understanding in Informed Consent, LEAP Africa and Mastercard Foundation Visit Pharmalys
Senegal Leads the Way: First Francophone African Country to Achieve WHO Maturity Level 3! We are thrilled to celebrate a significant achievement in global health and pharmaceutical innovation: Senegal has become the first Francophone country – and seventh country - in...
Pharmalys Capacity Building Programme in Nigeria and Sierra Leone, September 2024 to February 2025
Since September 2024, Pharmalys have conducted a series of capacity-building training sessions across four clinical research sites in Nigeria and Sierra Leone. Led by Mr. Assane Ndiaye and Mrs. Aissatou Ndour, the programme focused on equipping site staff with...
Did You Know That Africa Can Host Your Clinical Study? Pharmalys at the Clinical Outsourcing Summit 2025
At this year’s Clinical Outsourcing Summit (COS) in April 2025, Dr. Karim Bagaté, Director of Clinical Operations and Safety at Pharmalys, delivered a presentation on a topic very close to our hearts, titled “Did you know that Africa can host your clinical study?”....
Clinical Trials Day: Pharmalys on Building Inclusive Clinical Trials in Africa and Beyond
Each year on 20 May, Clinical Trials Day marks the anniversary of James Lind’s pioneering scurvy trial in 1747. More than 275 years later, clinical trials remain one of the most powerful tools we have for improving health outcomes, generating evidence, and shaping the...
Project Management Training: Pharmalys’ Commitment to Professional Growth
Pharmalys continues to invest in the professional development of its employees through dedicated training initiatives. A recent initiative is the Project Management Training Programme (PMBOK concept), led by Dr. Karim Bagaté, Director of Clinical Operations and Safety...
Pharmalys Strengthens Clinical Research Capacity in West Africa: Insights from the CECaBI II Workshop in Abidjan
As part of an ongoing commitment to strengthening clinical research standards across Africa, Pharmalys participated in the CECaBI II workshop, held on April 24 -25, 2025, in Abidjan, Côte d'Ivoire. The event was a key milestone in clinical research capacity building...
Senegal Leads the Way: First Francophone African Country to Achieve WHO Maturity Level 3!
We are thrilled to celebrate a significant achievement in global health and pharmaceutical innovation: Senegal has become the first Francophone country – and seventh country - in Africa to attain Maturity Level 3 (ML3) certification from the World Health Organization...